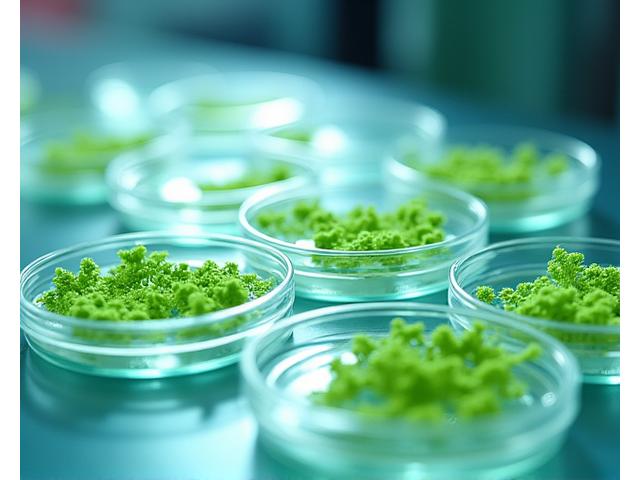

Rasai kuasa sains terdepan dengan skincare bioteknologi yang mengoptimumkan sel kulit anda pada tahap molekul.

Teratai Bumi menghadirkan breakthrough dalam skincare dengan bahan aktif yang diproduksi melalui fermentasi dan kultur sel tumbuhan untuk hasil yang luar biasa. Berbeza dengan bahan konvensional, bioteknologi membolehkan kami mencipta molekul yang lebih stabil, berkesan, dan mesra alam.
Memahami bagaimana bioteknologi Teratai Bumi bekerja untuk kulit anda pada tahap selular.

Proses fermentasi kami melibatkan penggunaan mikroorganisma terpilih untuk menukar bahan mentah semula jadi menjadi sebatian aktif yang sangat bioavailable. Ini meningkatkan penyerapan dan keberkesanan bahan pada kulit, memastikan nutrien penting dihantar terus ke sel-sel yang memerlukannya.
Menggunakan bioteknologi kultur sel tumbuhan, kami dapat menghasilkan bahan-bahan jarang dan berharga tanpa perlu menuai tumbuhan secara berlebihan dari alam semula jadi. Ini membolehkan kami mengekstrak potensi penuh tumbuhan sambil memastikan kelestarian alam sekitar, menghasilkan bahan aktif yang konsisten dan berkualiti tinggi.
Kedua-dua kaedah ini memastikan kestabilan molekul dan jangka hayat ramuan yang lebih baik dalam formulasi kami, memberikan anda produk yang konsisten dan berkesan setiap kali.
Terokai ramuan bioteknologi terkemuka yang terdapat dalam produk Teratai Bumi.
Gentle namun efektif, bahan ini memberikan manfaat anti-penuaan retinol tanpa kerengsaan. Ideal untuk kulit sensitif.

Memacu pembaharuan sel dan menggalakkan produksi kolagen untuk kulit yang lebih tegang dan muda.

Dihasilkan melalui fermentasi, ia menawarkan hidrasi unggul yang meresap lebih dalam untuk kulit gebu.

Menyokong mikrobioma kulit yang sihat, menguatkan halangan kulit dan mengurangkan keradangan.

Merangsang produksi kolagen dan elastin, menghasilkan kulit yang lebih gebu dan mengurangkan garis halus.

Komitmen kami terhadap sains disokong oleh penyelidikan yang ketat dan kerjasama pakar.

Setiap formulasi bioteknologi kami menjalani ujian klinikal yang ketat, dengan data sebelum dan selepas yang jelas menunjukkan peningkatan dalam kelembapan kulit, keanjalan, dan pengurangan garis halus. Kami komited untuk ketelusan, menyediakan hasil yang boleh anda percaya.

Teratai Bumi berbangga dengan kerjasama penyelidikan dengan universiti terkemuka dan endorsement daripada pakar dermatologi. Pendekatan berasaskan bukti ini memastikan produk kami bukan sahaja inovatif tetapi juga selamat dan berkesan untuk semua jenis kulit.
Bioteknologi bukan sahaja baik untuk kulit anda, tetapi juga untuk planet kita.

Dengan menghasilkan bahan aktif di makmal, kami mengurangkan kebergantungan kepada penuaian tumbuhan liar yang boleh membahayakan ekosistem. Ini mengurangkan jejak karbon kami dengan ketara dan menyokong kelestarian jangka panjang.

Proses bioteknologi kami direka untuk meminimumkan sisa dan memaksimumkan penggunaan sumber. Kami mengintegrasikan prinsip ekonomi kitaran, di mana produk sampingan dieksploitasi semula, mencipta ekosistem pengeluaran yang lebih cekap dan lestari.
Terokai produk unggulan kami yang diformulasikan dengan keajaiban bioteknologi. Revolusikan rutin penjagaan kulit anda hari ini.

Dengan ramuan fermentasi yang kuat, ia mengurangkan garis halus dan meningkatkan keanjalan kulit.
Beli Sekarang
Merangsang regenerasi kulit, memberikan hidrasi mendalam dan rupa yang segar.
Beli Sekarang
Menyokong keseimbangan mikrobioma kulit, membersih tanpa melucutkan kelembapan.
Beli Sekarang
Perlindungan UV termaju dengan bahan aktif bioteknologi yang tidak menyumbat pori.
Beli Sekarang